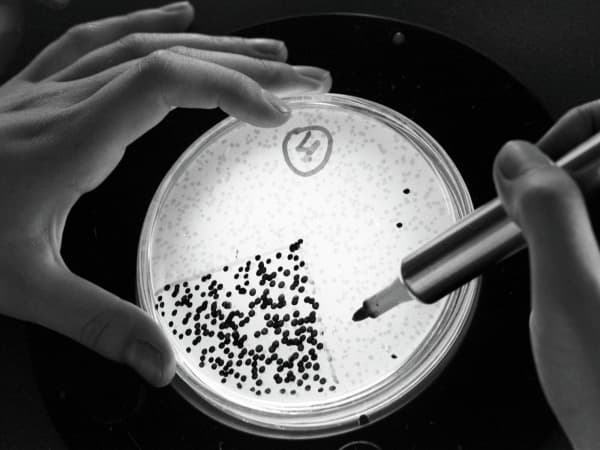
علماء يكتشفون علاجاً للسرطان بـ"البكتيريا المدربة"

أظهر فريق من الباحثين كيف أنه من الممكن لنوع واحد من البكتيريا، مع بعض الإرشادات، أن يكتشف سرطان الأمعاء أثناء تكونه في نماذج خلوية وحيوانية.
حاول العلماء تسخير بعض البكتيريا المبطنة للجهاز الهضمي لجعلها تعمل كمستشعرات "بروبيوتيك" الحيوية، والتي أظهرت نتائج واعدة بالفعل في مراقبة صحة الأمعاء والكشف عن نزيف الأمعاء والالتهابات وأورام الكبد، على الأقل لدى الفئران.
قام فريق بقيادة عالم الأحياء، روبرت كوبر، في جامعة كاليفورنيا، بهندسة البكتيريا لاكتشاف عينات الحمض النووي المتساقطة من خلايا سرطان القولون والمستقيم المزروعة في المختبر، وفي الفئران التي تحتوي على أورام القولون والمستقيم.
وقالت عالمة الطب الحيوي ومؤلفة الدراسة، سوزان وودز، من جامعة أديلايد في أستراليا: توضح هذه الدراسة كيف يمكن تصميم البكتيريا لاكتشاف تسلسل الحمض النووي المحدد، لتشخيص المرض في الأماكن التي يصعب الوصول إليها
.
اختار الباحثون بكتيريا "بايلي آ" المعروفة بقدرتها على التقاط الحمض النووي وتقوم عادة بالبحث عن طعامها بدمج قطع من الحمض النووي في الجينوم الخاص بها، والتي قد توفر وصفات جينية جديدة للبروتينات المفيدة.
قام الباحثون بتزويد "بايلي آ" بتعليمات للبحث عن تسلسلات جينية تحمل الطفرات، والتي توجد بشكل شائع في سرطانات القولون والمستقيم، ووجدوا أن بإمكانها تمييز الفرق بين الطفرات المسببة للسرطان والأخطاء الجينية غير الضارة في الحمض النووي للخلايا.
وتمت برمجة "بايلي آ" بحيث إذا وجد أي "دي إن إي" للورم، فإنه يدمجه في الجينوم الخاص به، ما يؤدي إلى تشغيل جين مقاوم للمضادات الحيوية، بحسب دراسة نُشرت في مجلة "ساينس أليرت" العلمية.
يقول وودز: يُظهر هذا البحث أنه يمكن استخدام نظام الاستشعار الحيوي لدينا للقبض على الحمض النووي لسرطان القولون والمستقيم داخل نظام بيئي معقد
.
تفترض الدراسة إعطاء البكتيريا المدربة عن طريق الفم ومن ثم الكشف الطفرات الحمض النووي، التي تدل على سرطان القولون والمستقيم وثلث سرطانات الرئة ومعظم سرطانات البنكرياس.
ترتفع معدلات الإصابة بسرطان الأمعاء لدى الأشخاص الذين تقل أعمارهم عن 50 عاماً.